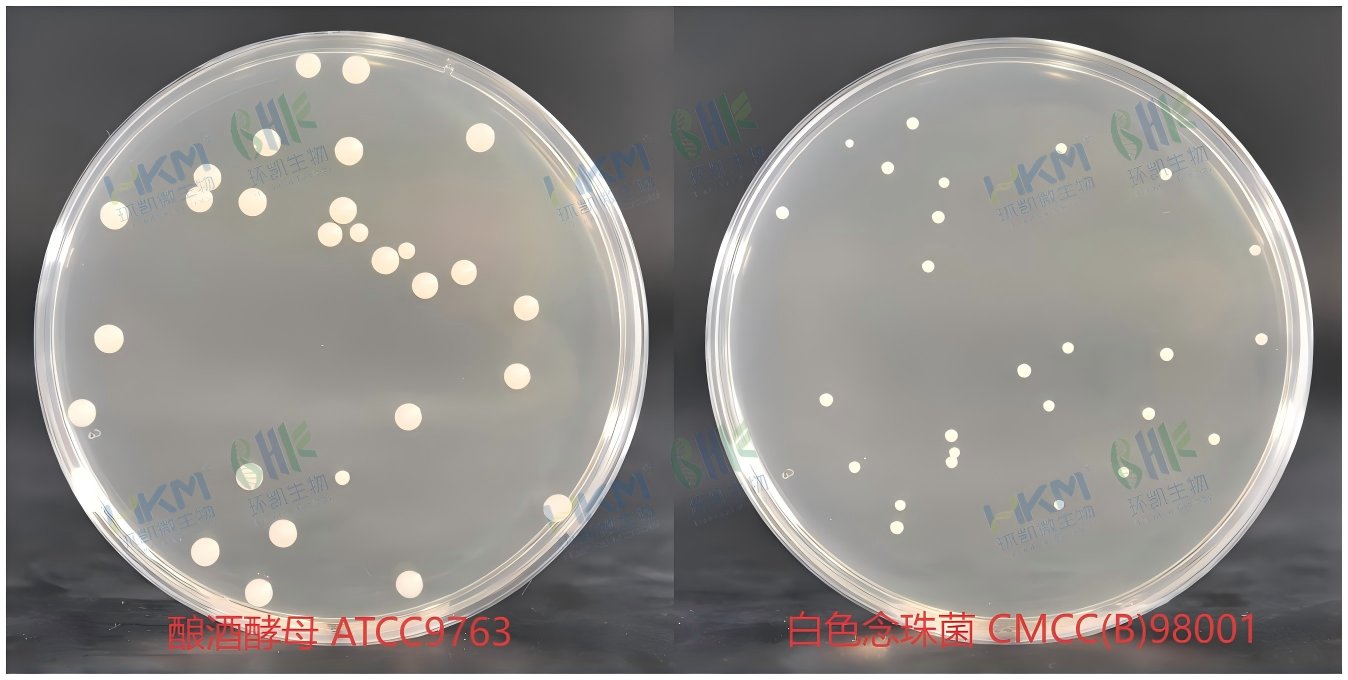
产品细节图片4

相关产品推荐更多 >
万千商家帮你免费找货
0 人在求购买到急需产品
- 详细信息
- 文献和实验
- 技术资料
- 库存:
99999
- 英文名:
Yeast Extract Peptone Dextrose Agar
- 保质期:
有效期见于产品标签
- 供应商:
环凯
- 保存条件:
贮存于避光、干燥处,用后立即旋紧瓶盖
- 规格:
250g/瓶
产品名称:酵母浸出粉胨葡萄糖琼脂培养基(YPD)
英文名称:Yeast Extract Peptone Dextrose Agar
其它叫法:YPD琼脂培养基
产品编号与包装规格:
| 产品编号 | 产品类型 | 包装规格 |
|---|---|---|
| 021100 | 干粉 | 250g/瓶 |



产品用途:用于酵母菌的培养,及供药品和生物制品中含王浆和蜂蜜的合剂酵母菌数测定用。
检验原理:胨提供碳源和氮源;酵母浸出粉提供B族维生素能促进生长;葡萄糖提供能源;琼脂是培养基的凝固剂。
酵母浸出粉胨葡萄糖琼脂培养基(YPD)配方成分:
| 配方(每升) | 含量 |
|---|---|
| 胨 | 10.0g |
| 酵母浸出粉 | 5.0g |
| 葡萄糖 | 20.0g |
| 琼脂 | 14.0g |
| 最终pH 6.0±0.2 | |
使用方法:称取本品49.0g,加入蒸馏水或去离子水1 L,搅拌加热煮沸至完全溶解,分装三角瓶,121℃高压灭菌20min,备用。
酵母浸出粉胨葡萄糖琼脂培养基(YPD)质量控制(下列质控菌株接种待测试培养基,20-25℃,72h结果如下:):
| 指标 | 质控菌株及编号 | 生长率 | 特征性反应 |
|---|---|---|---|
| 生长率 | 白色念珠菌 CMCC(B)98001 | PR:0.5~2.0 | 奶油色菌落 |
| 酿酒酵母 ATCC9763 | PR:0.5~2.0 | 奶油色菌落 |
储存条件与保质期:贮存于避光、干燥处,用后立即旋紧瓶盖;保质期三年。
参考文献:《中华人民共和国药典》2010年版
酵母浸出粉胨葡萄糖琼脂培养基(YPD) 相关产品(用于真菌(霉菌、酵母、食用菌)检测):
| 产品名称 | 产品货号 | 规格 | 产品说明及用途 |
|---|---|---|---|
| 沙氏琼脂培养基 Sabouraud Dextrose Agar with Antimicrobics |
021090 | 250g | 用于真菌的分离培养,还用于一次性使用卫生用品真菌菌落总数检测(GB) |
| 沙氏液体培养基 Sabouraud Dextrose Broth with Antimicrobics |
021091 | 250g | 用于真菌的分离培养,还用于一次性使用卫生用品真菌定性检测(GB) |
| 查氏培养基 Czapek-Dox Agar |
021020 | 250g | 用于培养能以硝酸盐作为唯一氮源的真菌和细菌,及青霉和曲霉等霉菌的分离培养和形态鉴别(GB) |
| 高盐察氏培养基 Salt Czapek-Dox Agar |
021030 | 250g | 用于饲料中霉菌的检测(GB) |
| 马铃薯葡萄糖水(PDB) Potato Dextrose Broth |
021053 | 250g | 用于真菌的培养及椰毒假单细胞菌酵米面亚种的检验(GB、IOS、美国FDA) |
| 无糖马铃薯琼脂 Potato Infusion Agar |
021060 | 100g | 用于霉菌培养(GB) |
| 霉菌液体培养基 Mold Liquid Medium |
021070 | 250g | 用于霉菌、酵母菌的增菌和培养 |
| 麦芽汁培养基 Malt Extract Medium |
021120 | 250g | 供酵母菌的增菌培养用(GB) |
| 麦芽汁琼脂培养基 Malt Extract Agar |
021110 | 250g | 供酵母菌的培养、鉴定及保存菌种用(GB) |
| 麦芽汁琼脂培养基(无抗生素) Wort Agar(Antibiotic Free) |
021112 | 250g | 用于霉菌培养(GB) |
| 麦芽浸膏汤 Malt Extract Broth |
027130 | 250g | 用于酵母和霉菌的培养,还用于酸性罐头食品商业无菌检验(GB) |
| 酵母葡萄糖氯霉素琼脂 Yeast Chloramphenicol Glucose Agar |
021103 | 250g | 用于乳及乳制品酵母菌、霉菌的计数(GB) |
| 酵母葡萄糖土霉素琼脂基础 Yeast Terranycin Glucose Agar Base |
021104 | 250g | 用于乳及乳制品酵母菌、霉菌的计数,临用前需加入配套试剂(SR0620)(SNT 2552.3) |
| M-绿色酵母和霉菌肉汤 M-Green Yeast and Mold Broth |
021042 | 250g | 用于啤酒厂、饮料厂、实验室、水质监测部门的滤膜法计数样品中的真菌(IOS) |
| 酵母提取物琼脂 Yeast Extract Agar |
028079 | 500g | 用于测定水中细菌、酵母菌、霉菌菌落总数(IOS9038-1-2000) |
| 沙氏葡萄糖琼脂(SDA)培养基 Sabouraud Dextrose Agar |
021099 | 250g | 用于霉菌和酵母菌培养及总数计数(2020版CP、ISO、EP、USP、美国FDA、WS) |
| 沙氏葡萄糖液体培养基 Sabouraud Dextrose Broth |
021096 | 250g | 用于霉菌和酵母菌培养(2020版CP、ISO、EP、USP、美国FDA) |
| 马铃薯葡萄糖琼脂(PDA) Potato Dextrose Agar |
021052 | 250g | 供霉菌和酵母菌计数及分离培养(2020版CP) |
| 玫瑰红钠琼脂培养基 Rose Bengal Agar Ⅱ |
021011 | 250g | 供药品及生物制品中霉菌和酵母菌的计数、分离、培养用(2020版CP) |
| 念珠菌显色培养基(药典) Chromogenic Candida Agar |
CRM016 | 1000mL | 用于念珠菌特别是白色念珠菌的选择性分离和初步鉴别(2020版CP) |
| 1%聚山梨酯80-玉米琼脂培养基 Corn Meal Infusion Agar With 1% Polysorbate 80 |
021105 | 100g | 用于念珠菌的鉴别,临用前需加入配套试剂(SR0410)(USP、CP、ISO) |
| 改良马丁培养基(真菌培养基) Martin Broth,Modified |
021040 | 250g | 用于真菌培养及药品和生物制品无菌检查用(CP) |
| 改良马丁琼脂培养基(真菌营养琼脂培养基) Fungi Agar |
021041 | 250g | 用于真菌培养及药品和生物制品无菌检查用(CP) |
| 孟加拉红(虎红)琼脂 Rose Bengal Agar |
021010 | 250g | 供霉菌和酵母菌的计数、分离、培养用(GB、SN、化妆品卫生规范) |
| 马铃薯葡萄糖琼脂(PDA)(添加抗生素) Potato Dextrose Agar |
021050 | 250g | 供霉菌和酵母菌计数及分离培养(GB、ISO、美国FDA) |
| 氯硝胺18%甘油(DG18)琼脂 Dichloran 18% Glycerol Agar |
021115 | 250g | 用于嗜渗酵母酵母菌,特别是蜂蜜中嗜渗酵母的选择性分离培养 |
| 念珠菌显色培养基 Chromogenic Candida Agar |
CRM010 | 1000mL | 用于念珠菌特别是白色念珠菌的选择性分离和初步鉴别(WS) |
风险提示:丁香通仅作为第三方平台,为商家信息发布提供平台空间。用户咨询产品时请注意保护个人信息及财产安全,合理判断,谨慎选购商品,商家和用户对交易行为负责。对于医疗器械类产品,请先查证核实企业经营资质和医疗器械产品注册证情况。
文献和实验参考文献:《中华人民共和国药典》2010年版
参考文献:《中华人民共和国药典》2010年版
至7.0,再补足水至1L。注:琼脂 平板需添加琼脂粉12g/L,上层琼脂平板添加琼脂粉7g/L。 YPD培养基 将下列组分溶解在0.9L水中: 蛋白胨20g 酵母提取物10g 葡萄糖20g 用水补足体积为1L后,高压灭菌。建议在高压灭菌之前,对色氨酸营养缺陷型每升培养基添加1.6g色氨酸,因为YPD培养基是色氨酸限制型培养基。为了配制平板,需要在高压灭菌前加入20g琼脂 粉。
成份: 蛋白胨 10克 大豆胨 3克 口胨 10克 消化血清粉 13.5克 酵母浸液 5克 牛肉膏 2.2克 牛肝膏 1.2克 葡萄糖 3克 KH2PO4 2.5克 氯化钠 3克 可溶性淀粉 5克 L-半胱胺酸盐酸盐 0.3克 硫乙醇酸钠 0.3克 琼脂 1.5克 DW 1000毫升 调PH7.2--7.4,10分钟高压灭菌. 注意:1可溶性淀粉加热易成糊状凝块,最好先用水少许将淀粉混匀,再加沸水使成糊状,备用. 2此培养基营养丰富,无需加促进
水 1000毫升 自然pH 分装,加棉塞,高压蒸汽灭菌。常用于培养霉菌。 8.豆芽汁葡萄糖(或蔗糖)培养基 黄豆芽 100克 葡萄糖 50克 琼脂 15克 水 1000毫升 称取新鲜黄豆芽100
技术资料









